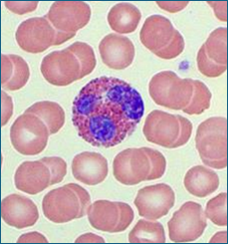
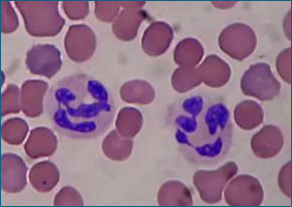

Haematology - Leucocyte Morphology: Granulocytes
1/11
Earn XP
Description and Tags
BEN IS GREAT! Basophil Eosinophil Neutrophil
Name | Mastery | Learn | Test | Matching | Spaced |
|---|
No study sessions yet.
12 Terms
Where are Basophils produced?
In the bone marrow, very low numbers within the blood of healthy animals (approx. <1%)
Appearance of a Basophil
Purple nucleus with blue granules

What do Basophils contain to reduce blood clotting + what do they manufacture?
Contain heparin to reduce blood clotting
Manufacture histamine
Promoting blood flow to tissues through vasodilation
Basophilia is .. and can be caused by ..
An abnormal abundance of basophils
Allergic reactions and myeloproliferative conditions
Where are Eosinophils produce and what are there levels within the bloodstream?
Produced in the bone marrow
Relatively low numbers within the bloodstream (approx. 4%)
Appearance of Eosinophils
Purple bi-lobed nucleus with red/orange granules
What are Eosinophils involved in?
Allergic responses and immunity against parasites
Where are Neutrophils produced?
In the bone marrow and release into the blood stream one mature
What is the dominant leucocyte in dogs and cats?
Full mature neutrophils (approx. 65%)
What is the appearance of Neutrophils?
Segmented purple nucleus and pink pale granules
An increase in the number of circulating ‘band’ immature neutrophils (horse-show shaped nucleus) indicates what?
Acute inflammation or infection
Neutrophils are ..
Phagocytes